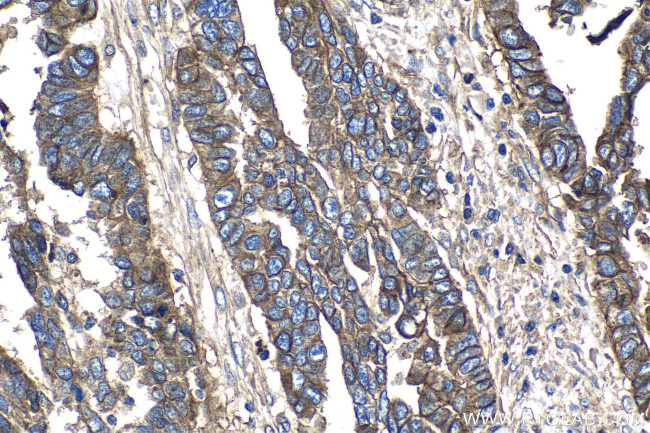
CD151 Antibody in Immunohistochemistry (Paraffin) (IHC (P))

Search
Proteintech
CD151 Polyclonal Antibody
{{$productOrderCtrl.translations['antibody.pdp.commerceCard.promotion.promotions']}}
{{$productOrderCtrl.translations['antibody.pdp.commerceCard.promotion.viewpromo']}}
{{$productOrderCtrl.translations['antibody.pdp.commerceCard.promotion.promocode']}}: {{promo.promoCode}} {{promo.promoTitle}} {{promo.promoDescription}}. {{$productOrderCtrl.translations['antibody.pdp.commerceCard.promotion.learnmore']}}
产品信息
27816-1-AP
种属反应
宿主/亚型
分类
类型
抗原
偶联物
形式
纯化类型
保存液
内含物
保存条件
运输条件
产品详细信息
Immunogen sequence: AYYQQLNTEL KENLKDTMTK RYHQPGHEAV TSAVDQLQQE FHCCGSNNSQ DWRDSEWIRS QEAGGRVVPD SCCKTVVALC GQRDHASNIY KVEGGCITKL ETFIQEHLR
靶标信息
The protein encoded by this gene is a member of the transmembrane 4 superfamily, also known as the tetraspanin family. Most of these members are cell-surface proteins that are characterized by the presence of four hydrophobic domains. The proteins mediate signal transduction events that play a role in the regulation of cell development, activation, growth and motility. This encoded protein is a cell surface glycoprotein that is known to complex with integrins and other transmembrane 4 superfamily proteins. It is involved in cellular processes including cell adhesion and may regulate integrin trafficking and/or function. This protein enhances cell motility, invasion and metastasis of cancer cells. Multiple alternatively spliced transcript variants that encode the same protein have been described for this gene.
仅用于科研。不用于诊断过程。未经明确授权不得转售。
篇参考文献 (0)
生物信息学
蛋白别名: CD 151; CD151; CD151 antigen; CD151 antigen (Raph blood group); CD151 molecule; GP27; hemidesmosomal tetraspanin CD151; Membrane glycoprotein SFA-1; PETA-3; platelet endothelial tetraspan antigen-3; platelet surface glycoprotein gp27; platelet-endothelial cell tetraspan antigen 3; Platelet-endothelial tetraspan antigen 3; Tetraspanin-24; Tspan-24; unnamed protein product
基因别名: CD151; EBS7; GP27; MER2; PETA-3; Peta3; RAPH; SFA-1; SFA1; TSPAN24
UniProt ID: (Human) P48509, (Rat) Q9QZA6, (Mouse) O35566
Entrez Gene ID: (Human) 977, (Rat) 64315, (Mouse) 12476